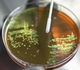

Business
Indian rupee to appreciate to Rs 82–82.50 in FY25: CARE Ratings

Chennai, April 25
The Indian rupee is expected to appreciate to about Rs 82–82.50 in FY25 while in the near term, it will trade between Rs 83-83.50 against the US dollar, a top economist with CARE Ratings said.
According to Chief Economist Rajini Sinha, the Indian rupee is expected to trade between Rs 83-83.50 in the near term, though geopolitical tensions may pose a potential risk.
"We expect INR to appreciate marginally during FY25 to about Rs 82-82.50, supported by India’s strong fundamentals in terms of healthy economic growth of around 7 per cent, a comfortable CAD (current account deficit) of around 1 per cent of GDP (gross domestic product), and an expected surge in FPI (foreign portfolio investment) inflows post India’s inclusion in global bond indices," she said.
Sinha said while concerns regarding the Iran-Israel tensions have eased, a strong dollar continues to weigh on emerging market currencies including the Indian rupee.
She said in the year so far, the rupee remains a top performer compared to some emerging markets and Asian peers, likely supported by RBI interventions.
Markets have trimmed their Fed rate cut expectations following robust economic data and higher-than-expected inflation in the US. Moreover, recent commentary from Fed officials has been hawkish, Sinha said.
Market attention is now focused on the release of US GDP data on Thursday and personal consumption expenditure inflation data on Friday, she said. The US economy is expected to show resilience. Headline inflation is expected to inch up slightly while core inflation is expected to show some moderation.
Any data surprises may cause market participants to revise their US Fed rate cut bets accordingly, Sinha said.